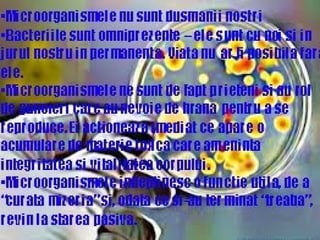
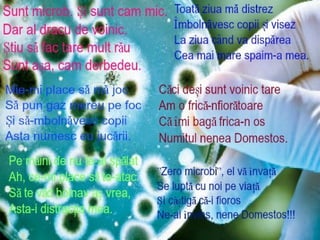
Microsoft power point presentation

More Related Content
PPTX
GeoLogics Corporate Profile PPTX
Git.mpp.2014 09.orientation.va.final PPT
PDF
PPT
DOCX
DOC
Tìm hiểu một số công nghệ web và xây dựng một chương trình newsletter PDF
Principals’ Attitudes towards ICT and Their Perceptions about the Factors Tha... Viewers also liked
PPTX
The RPG Dude on Open Display File Technology for your IBM i - GUI - DOM Control PPTX
Land capability classification PDF
PPTX
Ruta miquel martí i pol. Roda de ter PPTX
PPTX
Media powerpoint evaluation Jodie-Mae Howard PPTX
DOCX
PDF
M morton capabilities statement PPTX
PDF
Jelecos: Achieving Compliance with Axcient PPTX
DOCX
PPT
DOCX
Ministerul sanatatii din republica moldoldova More from Denis Lanciu
PPT
PPT
Protectia mediului material didactic PPT
PPT
PPT
PPT
от иры гарабажиу и рома федоришин PPT
PPTX
PPT
Teoriacreaionist 130522153616-phpapp01 PPT
PPT
PPT
PPT
PPT
Cum a aparut viata pe pamant 2 PPT
PPTX
Astăzi se conturează cinci ipoteze de bază despre PPTX
DOCX
Test de evaluare la biologie DOCX
DOCX
контрольная работа по теме Recently uploaded
PDF
Doing KPIs Right: a KEY to Analytics (and AI!) Impact! PDF
Top 1 0 Websites to Buy Verified Transfer Remitly Accounts ....pdf DOCX
A Complete Manual for Bulk Buying Old Gmail Accounts.docx PDF
Nicky Oppenheimer World Economic Forum Jan 2000 PDF
Buy Proton Mail Accounts _ Secure Email Accounts In 2026.pdf DOCX
How Verified Cash App Accounts Work and How to Buy.docx DOCX
Buy Verified Wise Account_ Top 11 Guide in the USA.docx PDF
Designing Business Model for Deep Tech Startups PDF
Kirill Klip GEM Royalty TNR Gold Lithium Presentation DOCX
Best 19 Sites to Buy Old Gmail Accounts .docx PDF
Camil Institutional Presentation_Dez25.pdf PDF
Camil Institutional Presentation_Dez25.pdf PDF
Best Top 3 Sites to Buy Google Reviews (5-Star & Non-Drop).pdf PDF
The threat to financial insitutions of quantum computing breaking all encrypt... PDF
What are the Key Benefits of Using iPads in Education.pdf DOCX
Best Place to Buy Facebook Account Verified Social Media Accounts.docx DOCX
Podcast Promotion Schedule for Turntable News PPTX
Finding Product-Market Fit in the Age of AI PDF
How To Buy Verified Cash App Accounts - Secure Your Transactions.pdf PDF
BendelPuertoRicoCubaGuyanaVenezuelaPetroleumRefineryPetrochemicalPetroAgroInd...